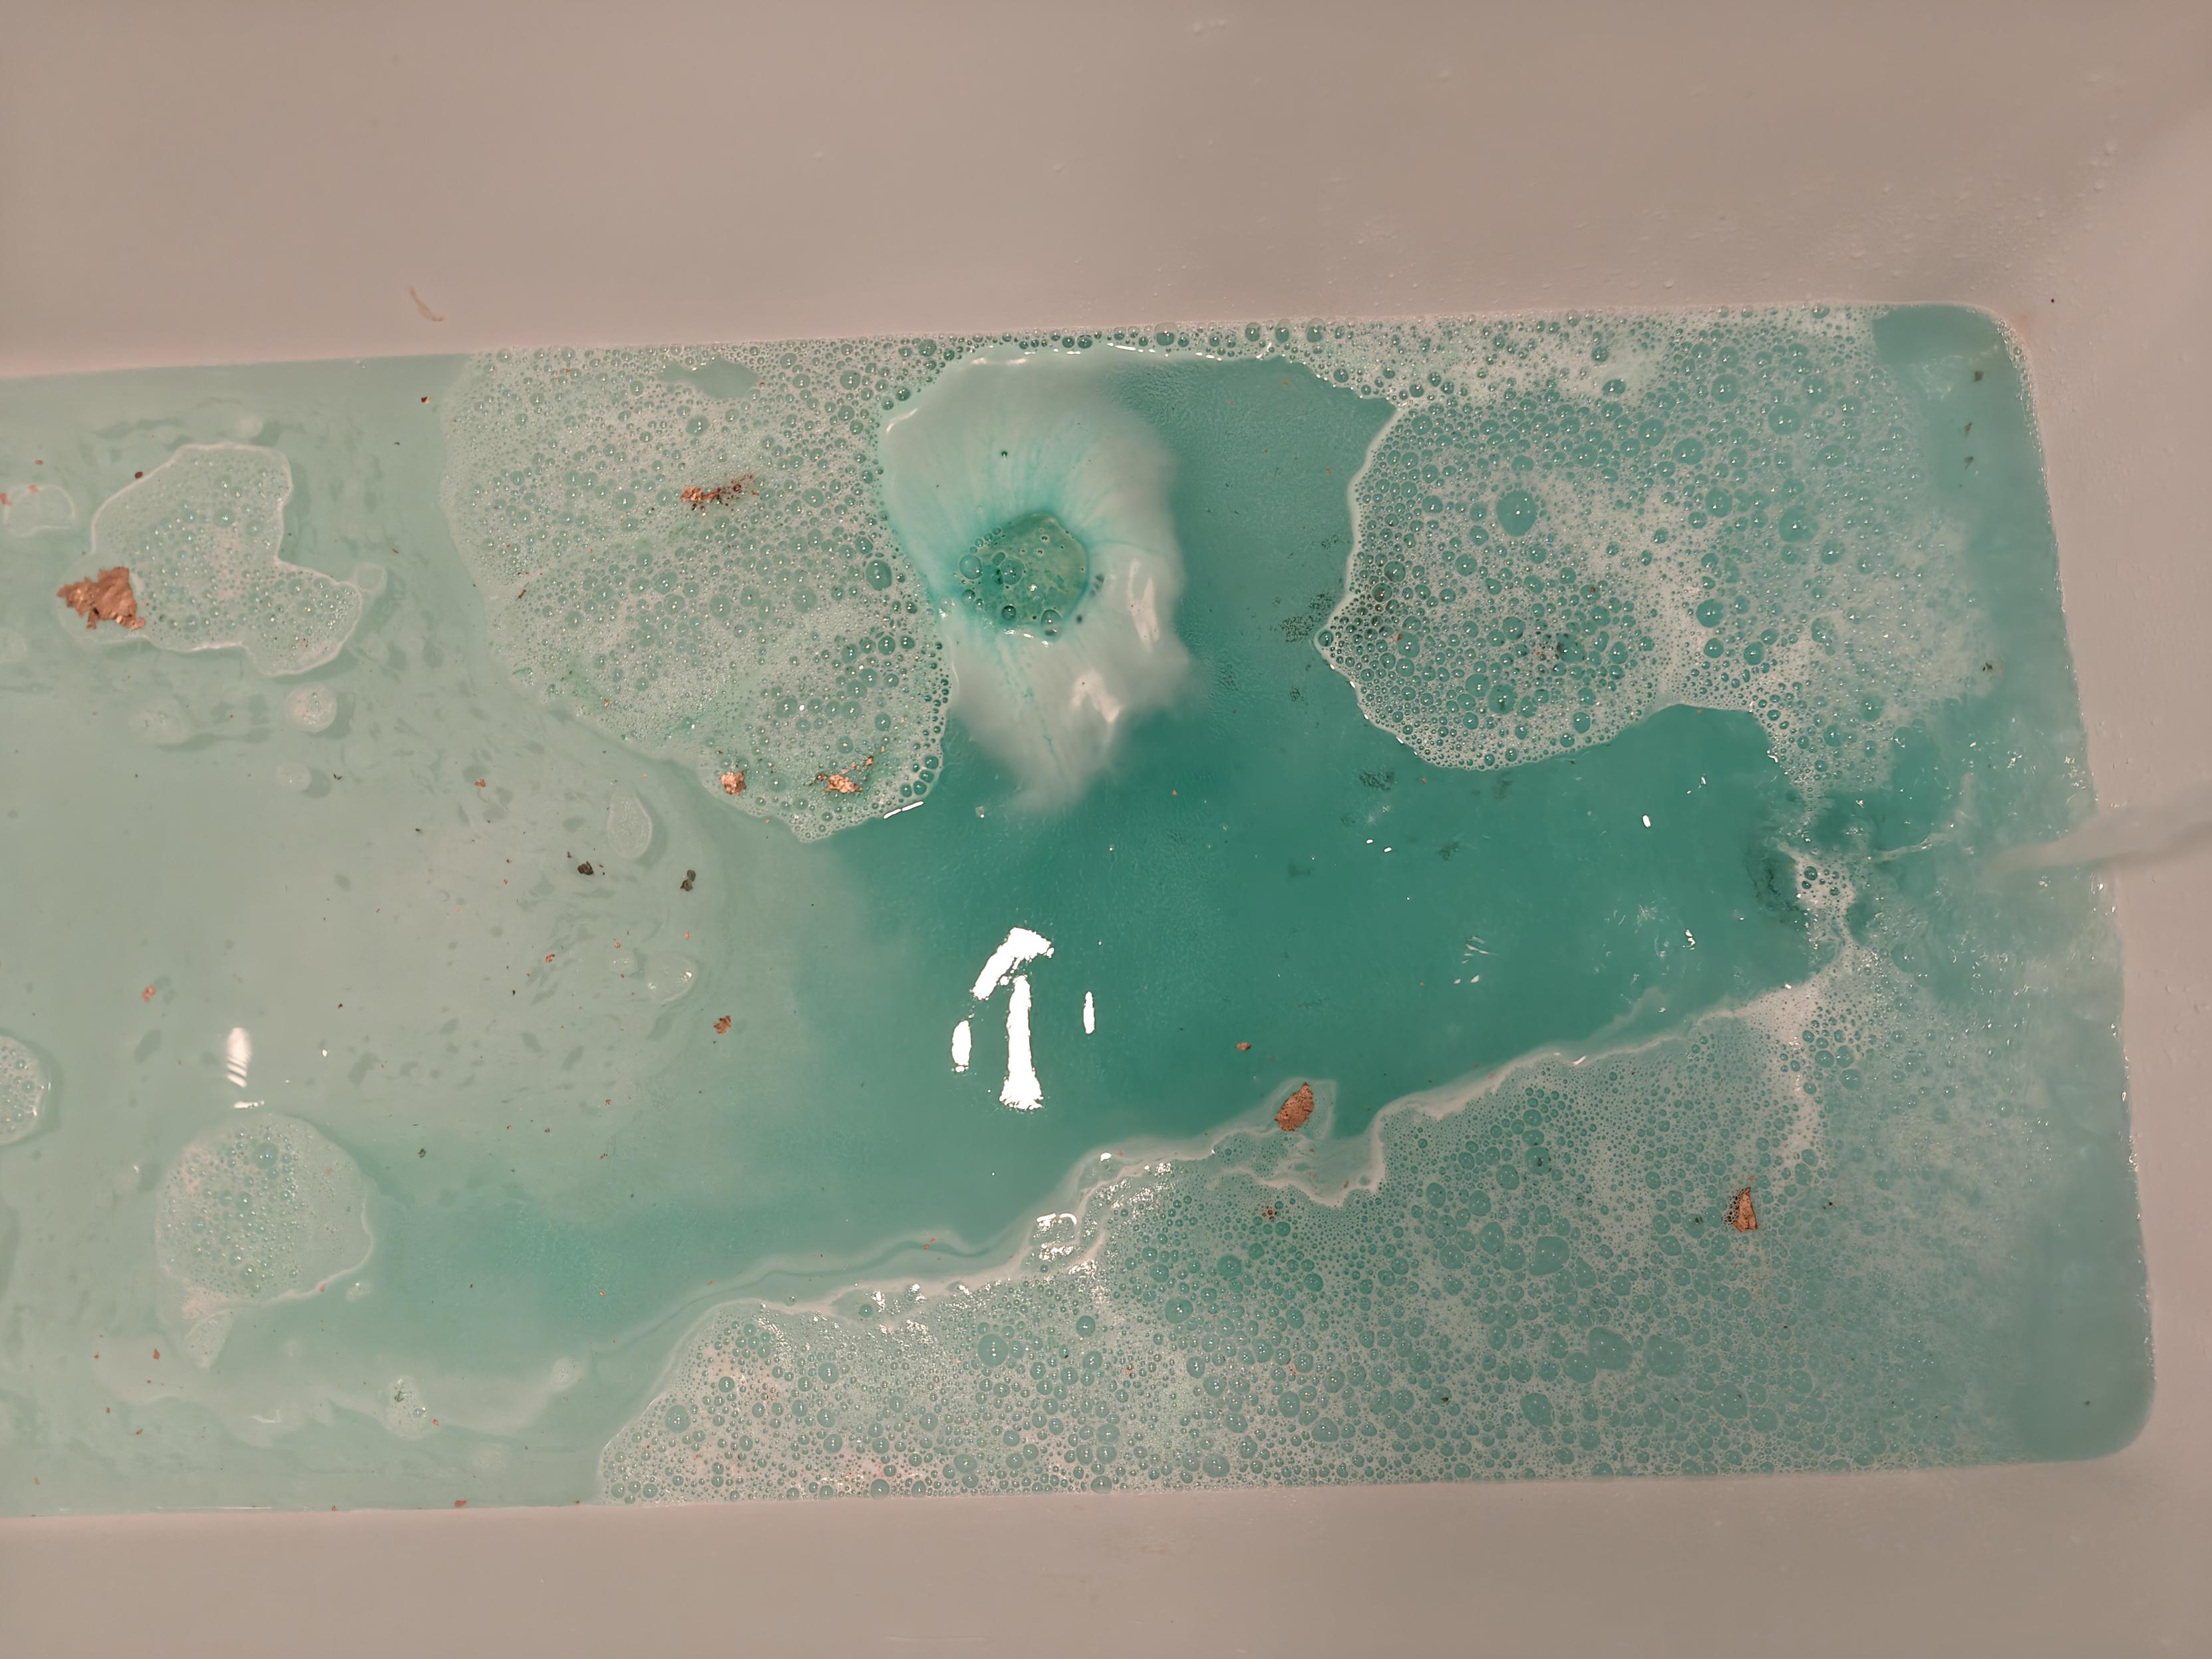

螺蛳粉 1120 大卡,宛禾砂锅刀削面 535,肥汁米线 268,how is that possible 这也差太多了吧明明感觉这几个吃的都差不多啊………是不是都瞎标的啊……(不是的话我要告别螺蛳粉 了
人老椒黄养生修仙
昨天时隔多年去爬墙,今天左半边 upper back 巨酸右半边几乎没感觉,难道左边比右边弱这么多所以用力多这么多!(也有可能是某条线左手比较用力啦毕竟不是一个对称训练的运动
(平时在家举铁因为只能用自重和哑铃其实都很少能感觉到背被练到,我是不是应该多开发一些自重训练技能(
健康养生 101 https://blog.douchi.space/wellness-101/?utm_source=douchi.space
比起努力不一定有回报的工作,一顿操作猛如虎还能亏得妈都不认识的股市,掏心掏肺却不一定称心如意的亲密关系,自己的健康是一分耕耘一分收获的大 deal 了。
步入 30 的 5 年来新增的最大一个技能点就是健康方面的知识技巧,而且不学不知道一学发现好多人(以及过去的自己以及可能的将来再回头看的现在的自己)对健康方面的认知或者至少说是行动力少得吓人,索性乘着 patreon 金主们的垂青也来写一篇 wellness 101 吧。
本文是我 2024 年 11 月 Patreon 的月度选题。加入 patreon 可以跟其它赞助者一起选出下个月你想看的博客文章,并且支持本博客的持续创作。下期选题已经发布欢迎金主点击投票 https://www.patreon.com/posts/2025-nian-12-yue-144646282 :
- 个人动画片 tier list
- 个人 2020s 电影 tier list
- 值得思考的问题
今天去 Elliot Bay 旁边的 trail 溜达,感觉这地方除了太晒之外其它的都挺好,毫无坡度,路是 paved,风景也好看(港口和船、市区、Space Needle、Rainier 都能看见),旁边还有 Expedia 的免费停车场真不错。今天旁边停了两辆大邮轮一个大货船十分繁忙。远处的 Rainier 若隐若现差点没看见。
另外新买的 echo hoodie 真不错,后来我单程跑回去取车也没特别热(当然本来没想要跑步穿着厚裤子来的结果就是腿在桑拿),当然就是我全程带着帽子据富婆说像古装剧里的尼姑(。没看手表心率发现第一次跑 tempo run 也有了最速 1 mile。
开个拳击串儿~ 🥊 

上回说到第一次去尝试 bag boxing https://douchi.space/@mtfront/114824364412925438 ,打完就心想晚点要肩和背酸爆炸了。今天起来果然就开始酸了,并且在下午逐步加深。出门往身上套运动 bra 和背心的时候就感觉手都不咋抬得起来……
而因为早先约的没注意到今天还有个 Barry's 的 double floor (没跑步只举铁,我感觉这个不适合我……)chest, back & abs……我感觉我人生举铁都没 push 这么狠过,meanwhile 旁边有个姐姐(尊称)跟我身型差不多举我两倍重量不带休息的……
练完我整个人回家在沙发上瘫了一晚上还没缓过来…… 现在体会到了人生中最酸的肩和背,平时自己在家练根本很难激活这俩地儿……估计明天手就抬不起来了现在我半夜痛定思痛决定去玩手机滚泡沫轴……
就你不得不说这钱花得还挺值(狂补蛋白中
Garmin 把年终总结放在 paywall 后面了,于是 reddit 上如雨后春笋地出现了大家自己做的年终总结网站,这是其中一款 https://garmin-wrapped.vercel.app/ (data 都是 local browser process 不太有 privacy concern,导出方法在 reddit 帖子上 https://www.reddit.com/r/Garmin/comments/1pj3ueb/garmin_unwrapped/)
子宫没了之后卵细胞去哪了? https://blog.douchi.space/where-do-the-eggs-go/?utm_source=douchi.space
前两天跟象友说到,子宫没了之后,卵巢就在空中飘着吗?卵子去哪了呢?激素怎么继续进入体内的?之前我只是凭借医生给我的三言两语知道个大概,但一细聊还真是一问三不知,遂向 chatGPT 老师刨根问底一下,把这个构造给搞搞清楚。
今天去补牙时候量血压时隔多年又量出了比较低的血压(90/50),牙医 intern 还大惊又量了一遍结果也差不多。牙医进来说 hmmm 你是不是跑马拉松什么的。
说时隔多年是因为小时候贫血 + 体弱低血压进过 ER(literally 跟断胳膊断腿的人一起打吊针),之后几年也是一发烧生病就低血压要晕倒。后来身体好了血压就比较正常了(90/60)。
现在头一遭又回到有点低的范畴了,不知道是老了身体开始重新变差了。肯定不贫血是能肯定的毕竟姨妈割了之后每年体检都是正常的。也没啥头晕之类的症状。难道我才跑步一年多就神功练成(?)了?(但主要是我跑步也没多厉害……难道我是什么天生耐力圣体……
之前在的公司都报销 one medical,现司不报销,于是今年就取消了。于是今年多大 hospital visit 都去的外面医院,体验实在是太差了,appointment 要推来推去好几个才找到合适的电话约上,过去还得操心停车以及走一大堆路找到医生 office,还得等 check in。最近到了年度体检时间想说这 one medical 的 $99 年费还是花上吧,虽然是额外支出但是能网上跟 0 人说话就能约和修改 appointment,时常能约到当天的,走路 2 分钟,不用等 check in,也能 walk in labs for blood work & vaccine,去一次 visit stress level 实在是比去医院小太多了。而且我之前去的这个大医院虽然器材全但要约复杂检查(CT ultrasound 之类)其实也是别的部门要另打电话预约,也不能当天直接解决,那跟我 one medical PCP refer 到外面专科去做有啥区别(甚至大医院看上 PCP 更麻烦)。
刚才想说赶老一岁前约个这几周的体检,结果发现 15 分钟后就有一个,连开会吃饭都不耽搁,半小时之内已经体检完回到家蹲在马桶的发这条嘟了。顿时感叹这钱花得太值了(不对甚至在 2 week trial 里还没花钱……)
今天体检抽血我又想起来要辱骂中国教育系统了。就我小时候血管抽不出来血每次抽血都要折腾半天,到后来中学严重到低血压晕倒要去急诊室打钾的程度,其它常见毛病贫血缺钙什么的常规操作就不说了,我当时一直以为我的人设就是体弱多病只能 deal with it,我妈还是护士按说健康常识 above average 但这种“体质问题”都只有看医生开药调理 + 补 supplement, 0 人提过让我锻炼 or 多吃蔬菜水果蛋白质。
直到我自己工作了以后开始自己接触健康常识才知道 cardio & diet & strength training is a thing。稍微锻炼 + 注重一下膳食平衡之后这几年抽血屁事没有一把过抽完还能去跑个步,血常规骨密度啥的我一个三十多好几年的人了比我十几二十岁时候都健康多了。什么先天不足,根本是正常手牌活脱脱在新手村里练废了自己出村了熬夜练级 + 氪金才给补回来……
哦对今天还拿到了今年的体检报告,结果很好甚至比前两年还更好了一些(之前有些稍微接近边缘一点的数值这次都向中间靠拢了但大概率是正常波动啦),过去一年多喝蛋白粉应该没给肾造成什么负担,,RBC 也比之前离下限更远了一些,不错(从源头消灭月经万岁!)。
唯一稍微有点 concerning 的是 A1c 还是离正常上限只差一点了,不过过去 3 年的检测结果都没变过也算是稳如老狗。concern 的点是我妈高血糖,我吃面区的习惯确实精碳水吃的比较多,现在年纪大了思考是不是得稍微控一下。难道要把面换成什么神奇的健康 whole grain 面了(有这种东西吗……)
最近白天都会一边膝盖有肿胀感,坐久了尤为明显,影响深蹲能蹲下去的程度,睡觉或者运动(跑步/划船机之类的用到腿的)反而会消失。今天去看 PT,让拉伸了 quads 和 hip flexor 果然立等可见减轻了  人体好神奇……(这就是 aging 吗……)
人体好神奇……(这就是 aging 吗……)
PT 夸我 squat 很棒没什么问题 
(今年 deductible 用完了一次 PT 6 刀我狠狠薅
年纪大了睡眠越来越脆弱,昨晚就吃饭晚了点(也没有特别临近睡觉吧就睡前三小时),早上一看前半夜睡眠质量都堪忧 deep sleep 也只有一点点 resting heart rate 也很高  哪像以前大学时候半夜吃完烧烤宵夜照睡不误(虽然说那时候也没有手表监测睡眠就是了……)
哪像以前大学时候半夜吃完烧烤宵夜照睡不误(虽然说那时候也没有手表监测睡眠就是了……)
Mid 30s vs Mid 20s https://blog.douchi.space/mid-30s-vs-20s/?utm_source=douchi.space
因为后天努力(养生、健身、营养搭配、各种健康习惯)和自然积累(心理成熟度、财务),35 岁整体而言觉得自己跟 25 岁比起来是在一个更“好”的状态的。当然,时间不能倒流,南墙也永远要自己撞,倒也没有太多想要改或者后悔的地方。
时间可过的真快呀……
本文是我 2024 年 9 月 Patreon 的月度选题。加入 patreon 可以跟其它赞助者一起选出下个月你想看的博客文章,并且支持本博客的持续创作。下期选题已经发布欢迎金主点击投票https://www.patreon.com/posts/139526787 :
- 美国 adulting 101
- 我不再做的事
- 睡眠耳机是噱头吗 - Soundcore A30 测评
我们这儿的 classpass 居然出现了 DEXA scan  一次才 13 credit (约等于 27 刀吧),这也太便宜了
一次才 13 credit (约等于 27 刀吧),这也太便宜了  搞得我想从 annually 变成 quarterly 做了(搞得好像辐射不要钱似的!)
搞得我想从 annually 变成 quarterly 做了(搞得好像辐射不要钱似的!)
今天还和富婆去游泳了,这个泳池 happen to 有深水区,而且有没有 laps 的 open area 可以自由活动(赞美 green lake 泳池,出来就是湖也环境很不错,就是车可能稍微难停点),刚好富婆要给南极浮潜做准备,心一横就决定第一次尝试深水区了(我其实相信她的水平而且救生员也就在旁边但第一次去深水区是有一些 intimidating 的心理障碍需要克服)。后来我俩去找了一根长条 floaty,我试了一下环绕在身体周围还是卡在腋下或者是卷成 U 型压在手下面都很不错,但富婆试了试这个发现她拿着就不能正常游泳了。
后来富婆决定贴着墙 vibe 游泳心一横就出去了,我在旁边拿着 floaty 跟着。跟上去之后我突然开发出了一种方法,就是我侧着像飞天一样把这个长条 floaty 抻直,跟墙平行,跟着富婆同步前进,这样万一她没力了两边都可以抓。于是富婆拥有了可能是全西雅图最豪华的人肉 powered 动态泳道。
但富婆很优秀地全程都没有抓过!!!这个故事告诉我们(有一定实力的情况下)克服心理障碍 just do it 就成功一半了!
我也很优秀因为手抓着没法滑只有腿侧着蹬所以还挺费力的,于是我也得到了锻炼。我好优秀! 
最近有点关节滑膜炎症,久坐膝盖会僵硬肿胀,除了拉伸之外缓解方式还有把腿倒过来促进静脉回流。但不躺床又很少这个机会。于是现在的我找到了一个新的上网姿势……人老了身体可真是脆啊……
我也开始看「控糖革命」了,以下只是书里的内容没有额外求证如有纰漏欢迎指正。(以及这个书中文翻译读感还可以,但是科学上不是很严谨,比如“几百万年前地球上开始产生生命”这种低级错误…… 能明显感觉到是直接字面翻译了人家 millions years ago,但翻成中文这个错误也太大了啊给小朋友看到了怎么办……(?))
看到里面说由于糖的各种危害,所以如果一定 crave 小零食的话吃咸辣味小零食比吃甜味小零食对身体伤害小。
本 stress eating 咸辣小零食人士:yeeeeessssssss 
啊昨天泡澡泡了 4 个小时真舒服感觉整个人都泡透了,睡觉前就有用整个人都有在向外散发蒸汽的感觉,甚至持续到了今天早上起来  。持续低迷了好久的 HRV 也在昨晚恢复到了较高水平,高了一段时间的 resting heart rate 昨天也降到 50 以下了。前阵子 HRV 低 RHR 高我一直觉得压力来源是工作,周五六都只有轻度有氧算是 rest / recovery day 吧,突然感觉也可能是上周运动量也有点太大身体双重压力。现在又满血复活啦!
。持续低迷了好久的 HRV 也在昨晚恢复到了较高水平,高了一段时间的 resting heart rate 昨天也降到 50 以下了。前阵子 HRV 低 RHR 高我一直觉得压力来源是工作,周五六都只有轻度有氧算是 rest / recovery day 吧,突然感觉也可能是上周运动量也有点太大身体双重压力。现在又满血复活啦!
(以及一加这个相机真是和人眼色差还蛮大的……这个水肉眼看是没有争议的绿色,like 这是一个 Wicked 联名泡澡球所以它 100% 是 wicked 绿 have no reason to be teal,结果照出来变 teal 的了……)
肌肉真是用进废退。以前去 Barry's 很少肌肉酸因为反正我主要是去跑步的举铁就是辅助,每个部位也就练一点,重量和 rep 大课也很难到极限。放假回来三周没练了昨天去第一练,甚至都没用我平时自己举铁的重量。练完当场就开始酸,今天更是浑身都是酸的,平时很少酸的 bicep 和胸肌甚至都酸了…… 每个地方也就练了一两组而已而且也没到 failure 啊!

 练着练着我旁边的肌肉大哥们都开始走路了(
练着练着我旁边的肌肉大哥们都开始走路了(